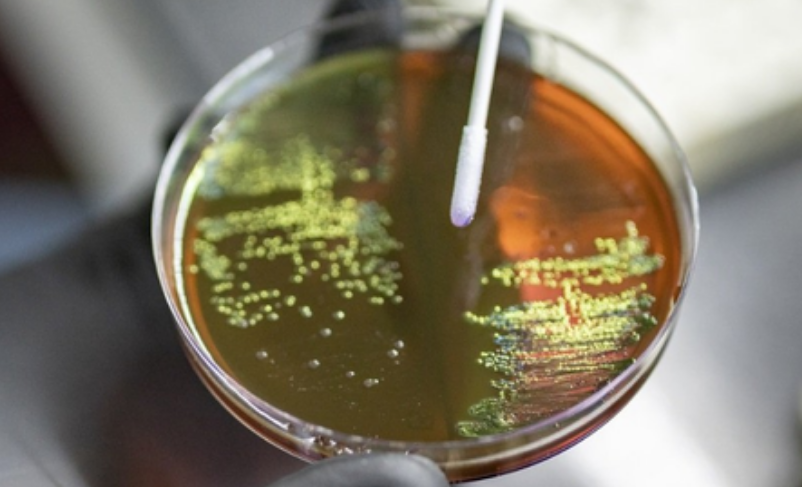

Study Links Antibiotic Use During Pregnancy to Higher Risk of Bacterial Disease in Newborns
NEW DELHI, India — Maternal use of antibiotics during pregnancy may increase the risk of newborns developing Group B Streptococcus disease, a common but potentially serious bacterial infection, according to a new international study.
Group B Streptococcus, or GBS, often lives harmlessly in the gut or genital tract, but it can cause severe infections in vulnerable populations, including newborns, older adults, and people with weakened immune systems. In infants, GBS can lead to life-threatening conditions such as sepsis, meningitis, and pneumonia.
The study, led by researchers from Sweden’s Karolinska Institutet and the University of Antwerp in Belgium, found that prenatal exposure to antibiotics was associated with a higher risk of neonatal GBS disease within four weeks of birth. The strongest link was seen when antibiotics were taken during the early third trimester of pregnancy.
“Prenatal antibiotic exposure can raise GBS risk within four weeks postpartum, especially in neonates not covered by risk-based intrapartum prophylaxis, with the early third trimester being a critical window of susceptibility,” the researchers wrote in the Journal of Infection.
The team conducted a population-based cohort study using national health registers in Sweden, covering all singleton live births between 2006 and 2016. The analysis included 1,095,644 live-born singletons, of whom about 24.5 percent were exposed to antibiotics before birth.
The incidence of GBS disease was higher among antibiotic-exposed newborns than among unexposed infants, at 0.86 versus 0.66 cases per 1,000 live births. The increased risk was particularly evident among infants without established GBS risk factors.
Researchers said the study is the first to specifically examine the link between prenatal antibiotic exposure and neonatal GBS disease. The findings are consistent with earlier Nordic studies that reported a 16 to 34 percent increased risk of infections during early childhood, between ages one and five, following antibiotic exposure in the womb.
The study also found that antibiotics active against GBS, when given close to delivery within four weeks, did not appear to protect newborns from developing the disease.
According to the researchers, the association between prenatal antibiotic exposure and neonatal GBS disease depended on whether clinical GBS risk factors were present, with a positive association observed only in pregnancies without such risk factors.
“This suggests that neonates without established GBS risk factors may benefit more from limiting prenatal antibiotic exposure,” the researchers said.
The team called for further research and stressed the need for closer monitoring of newborns who fall outside existing GBS prevention guidelines, particularly those exposed to antibiotics in utero during the early third trimester. (Source: IANS)



